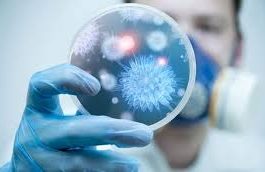
Công nghệ lên men

Sinh tổng hợp erythromycin
Đại cương
Erythromycin được nhóm các nhà nghiên cứu cảu hãng Lilly tách chiết từ chunge Streptomyces erythreus, sau này có tên là Sacccharopolyspora erthraea, vào năm 1949 và được đưa vào...
Tiêu chuẩn về thuốc
1. Nội dung chính của mộ tiêu chuẩn về thuốc.
Khái niệm tiêu chuẩn về thuốc: tiêu chuẩn về thuốc là một tiêu chuẩn đánh giá toàn diện, bao gồm rất nhiều...
Đại cương về sinh tổng hợp các penicillin tự nhiên
Penicillin
Các penicillin là đại diện tiêu biểu cho các kháng sinh có nguồn gốc từ nấm mốc. Ngoài ra, còn một vài kháng sinh khác như griseofulvin, trichotexin, fumagillin… cũng được...
Hệ thống kiểm tra chất lượng thuốc
Hệ thống kiểm tra chất lượng thuốc là hệ thống những cơ quan có thẩm quyền do nhà nước trao quyền có chức năng nhiệm vụ quyền hạn kiểm tra chất...
Công nghệ sinh học – Hạt nhân trung tâm ba thành phần
Công nghệ sinh học - Hạt nhân trung tâm ba thành phần
“ Công nghệ sinh học là sự kết hợp của các ngành khoa học tự nhiên và khoa học công...
Ảnh hưởng của các yếu tố dược học đến sinh khả dụng của thuốc...
Sự hấp thu ảnh hưởng đến sinh khả dụng của thuốc tiêm
Độ tan và tốc độ hòa tan
Chỉ có phần dược chất ở dạng dung dịch mới có khả năng khuếch...
Chất nhũ hóa dùng trong bào chế(phần 2)
Các chất nhũ hóa thường dùng
1.Các chất nhũ hóa thiên nhiên
2.Các chất nhũ hóa tổng hợp và bán tổng hợp
a.Các chất diện hoạt(chất nhũ hóa thực sự)
-Đặc tính chung là chúng...
Qúa trình phát triển của công nghệ sinh học
Qúa trình phát triển của công nghệ sinh học
Nhiều quá trình công nghệ sinh học hiện nay có nguồn gốc từ các quá trình lên men cổ truyền như lên men...
Khuấy trộn chất lỏng
Khuấy trộn là một kỹ thuật được dùng trong sản xuất hầu hết các dạng thuốc và có ảnh hưởng nhiều đến tiêu chuẩn chất lượng của sản phẩm hoàn thành....
Công nghệ sinh học – Một sự theo đuổi đa ngành
Công nghệ sinh học – Một sự theo đuổi đa ngành
Công nghệ sinh học là sự ưu tiên của qúa trình theo đuổi đa ngành. Trong những thập kỷ gần đây,...